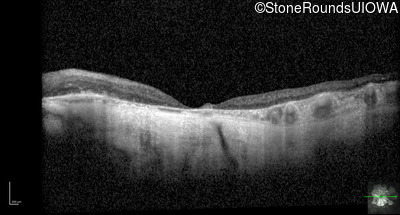
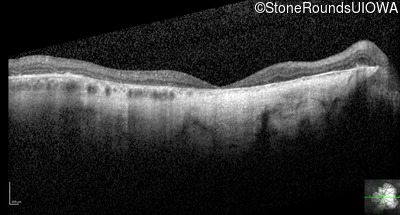
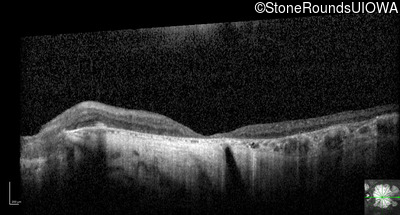
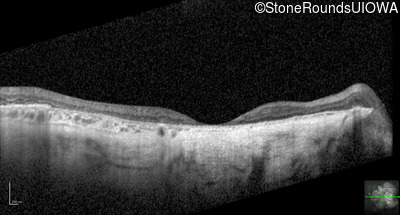
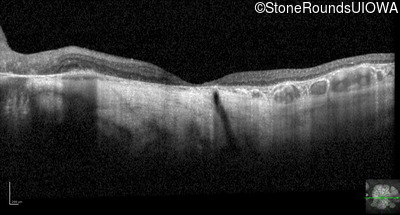
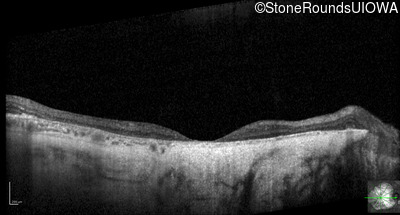
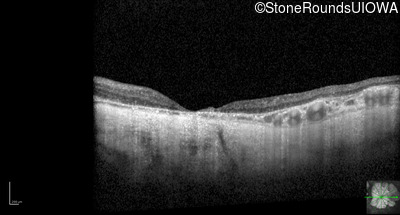

Case
SR2106
Student Mode
AD Stargardt Disease (IIF)
Male
Male
Hidden
SR2106
Student Mode
AD Stargardt Disease (IIF)
Male
Male
Visit at age: 22 years
Fundus Photography - Right - 20/100 -1
Exemplar

Fundus Photography - Left - 20/70 -1
Exemplar

Visit at age: 38 years
Goldmann Visual Field - Right - 20/200
Exemplar

Goldmann Visual Field - Left - 20/200
Exemplar

Visit at age: 43 years
Fundus Photography - Right - 20/150 OU
Exemplar

Fundus Photography - Left - 20/150 OU
Exemplar

Visit at age: 56 years
Fundus Photography - Right - 20/150 OU
Exemplar

Fundus Photography - Left - 20/150 OU
Exemplar

Visit at age: 76 years
Optical Coherence Tomography - Right - 20/150
Exemplar / OCT Stack

OCT Stack

Optical Coherence Tomography - Left - 20/150
Exemplar / OCT Stack

OCT Stack

Infrared Fundus Photograph - Right - 20/150
Exemplar

Infrared Fundus Photograph - Left - 20/150
Exemplar

Visit at age: 76 years (Visit 2)
Optical Coherence Tomography - Right - 10/160 sc
Exemplar / OCT Stack

OCT Stack

OCT Stack

Optical Coherence Tomography - Left - 10/100 sc
Exemplar / OCT Stack

OCT Stack

Infrared Fundus Photograph - Right - 10/160 sc
Exemplar

Infrared Fundus Photograph - Left - 10/100 sc
Exemplar

Visit at age: 78 years
Fundus Photography - Right - 20/400 sc
Exemplar

Fundus Photography - Left - 20/200 sc
Exemplar

Fundus Montage - Right - 20/400 sc
Exemplar

Fundus Montage - Left - 20/200 sc
Exemplar

Goldmann Visual Field - Right - 20/400 sc
Exemplar

Goldmann Visual Field - Left - 20/200 sc
Exemplar

Optical Coherence Tomography - Right - 20/400 sc
Exemplar / OCT Stack

OCT Stack

OCT Stack

Optical Coherence Tomography - Left - 20/200 sc
Exemplar / OCT Stack

OCT Stack

OCT Stack

Infrared Fundus Photograph - Right - 20/400 sc
Exemplar

Infrared Fundus Photograph - Left - 20/200 sc
Exemplar

Visit at age: 80 years
Optical Coherence Tomography - Right - 20/300
Exemplar / OCT Stack

OCT Stack

OCT Stack

Optical Coherence Tomography - Left - 20/500
Exemplar / OCT Stack

OCT Stack

OCT Stack

Infrared Fundus Photograph - Right - 20/300
Exemplar

Infrared Fundus Photograph - Left - 20/500
Exemplar

Case Level Images
Diagnosis & molecular findings
Allele 1:
Leu263 del5tttCTTAA
False Genotype Rate:
Gene Count:
Submit Final Diagnosis
Clear Diagnosis